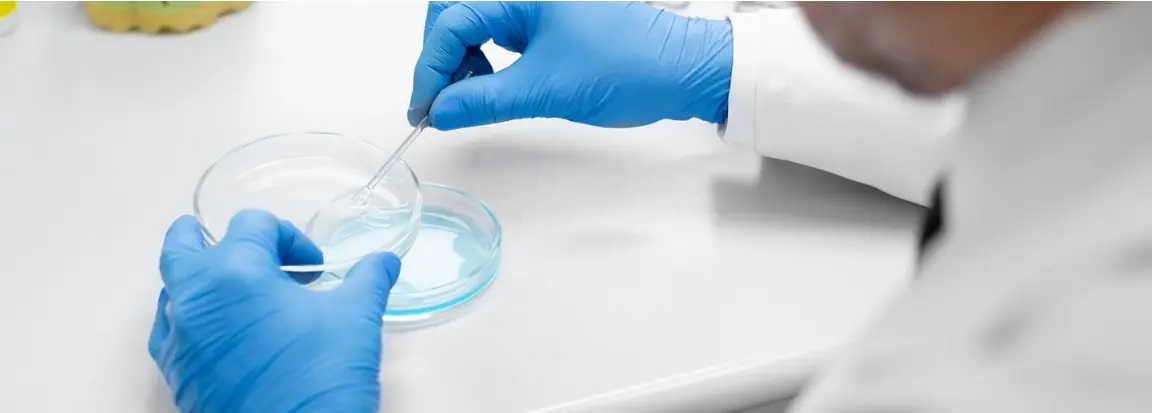
图片损坏

CYTOKIND
赛拓生物
赛拓生物建有约560平方米严格遵循GMP标准的现代化实验室,先进的设施设备与严谨的管理体系,为科研与生产活动提供坚实保障。依托高标准的科研平台,公司聚焦抗体发现、细胞培养试剂开发、ELISA试剂研发三大核心业务,构建起全方位、多层次的生物科技服务生态。
CYTOKIND
赛拓生物
在抗体发现领域,赛拓生物运用前沿技术手段,针对客户需求,高效筛选、优化高特异性抗体,助力生物医药研发、疾病诊断等领域的突破;细胞培养试剂开发方面,公司以多年行业经验与技术积累为依托,深入研究细胞生长特性,精心研制出性能卓越、质量稳定的细胞培养试剂,满足不同科研与生产场景需求;而在ELISA试剂研发上,赛拓生物不断探索创新,开发出灵敏度高、准确性强的检测试剂,广泛应用于科研实验、临床诊断等场景,为生命科学研究与医疗诊断提供可靠工具。

CYTOKIND
赛拓生物
此外,赛拓生物还积极开展传代细胞、杂交瘤细胞、干细胞和免疫细胞的基础研究与应用,以及单克隆抗体及检测试剂盒的研发工作,为科研机构、生物医药企业等合作伙伴提供全方位技术支持与解决方案。
作为一家充满活力的初创企业,赛拓生物秉持“创新、专业、合作、共赢”的理念,以市场需求和医疗诊断趋势为导向,持续加大研发投入,推动技术成果转化,力求为推动生物科技产业发展、提升医疗健康水平贡献力量。



